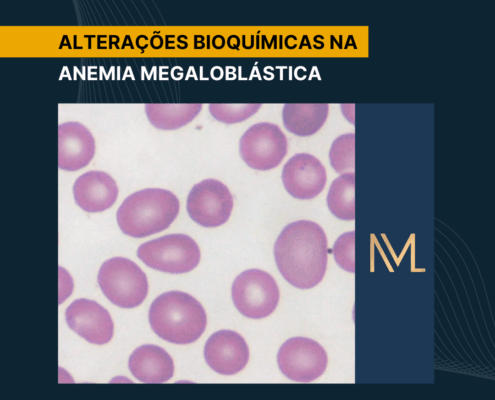

Papel da Urinálise e da Bioquímica na Infecção do Trato Urinário (ITU)
A Infecção do Trato Urinário é uma das mais comuns, ocorrendo na comunidade e em hospitais, podendo acometer desde a uretra até o parênquima renal. A via ascendente é a principal forma de contaminação, frequentemente por Escherichia…

Hemograma na Sepse
A sepse é uma condição crítica caracterizada por uma resposta inflamatória descontrolada diante de uma infecção, capaz de comprometer rapidamente vários órgãos. A evolução depende tanto do microrganismo, bem como das condições…
ALTERAÇÕES BIOQUÍMICAS NA ANEMIA MEGALOBLÁSTICA
A anemia megaloblástica é um tipo de anemia macrocítica caracterizada por alterações na síntese de DNA nos precursores eritroides, o que resulta em hemácias maiores e disfuncionais, tanto na medula óssea quanto na circulação periférica.…

Anemia falciforme
A anemia falciforme é uma das hemoglobinopatias hereditárias mais relevantes no Brasil, especialmente devido à nossa história de miscigenação, que ampliou a distribuição da hemoglobina S em diferentes regiões e grupos populacionais.…

PCR e VHS na atividade inflamatória
A inflamação é uma resposta fisiológica essencial para restaurar a homeostase diante de infecções, lesões ou outros estímulos nocivos, e durante esse processo citocinas como IL-6 e IL-1 estimulam a produção de proteínas de fase aguda,…

Diferenças entre pseudoplaquetopenia e plaquetopenia verdadeira
A pseudotrombocitopenia ou pseudoplaquetopenia é uma condição artefatual, caracterizada por uma contagem falsamente baixa de plaquetas em amostras de sangue coletadas em tubos contendo EDTA como anticoagulante. Esse fenômeno ocorre devido…

HEMÁCIAS NA URINA
A presença de hemácias na urina é um dos achados microscópicos mais relevantes na urinálise. Elas podem surgir em qualquer ponto do trato urinário, e em mulheres podem aparecer por simples contaminação menstrual. Por isso, interpretar…

MONONUCLEOSE INFECCIOSA
A mononucleose infecciosa, comumente conhecida como doença do beijo, é uma condição viral comum que afeta principalmente adolescentes e adultos jovens. Esta doença, causada principalmente pelo vírus Epstein-Barr, pode variar de leve a…

ANEMIA NA DOENÇA RENAL
A anemia é um achado comum em diversas doenças não hematológicas, especialmente na doença renal crônica. Essa condição afeta cerca de 1% da população e está frequentemente associada a causas como nefropatia diabética, nefropatia…
